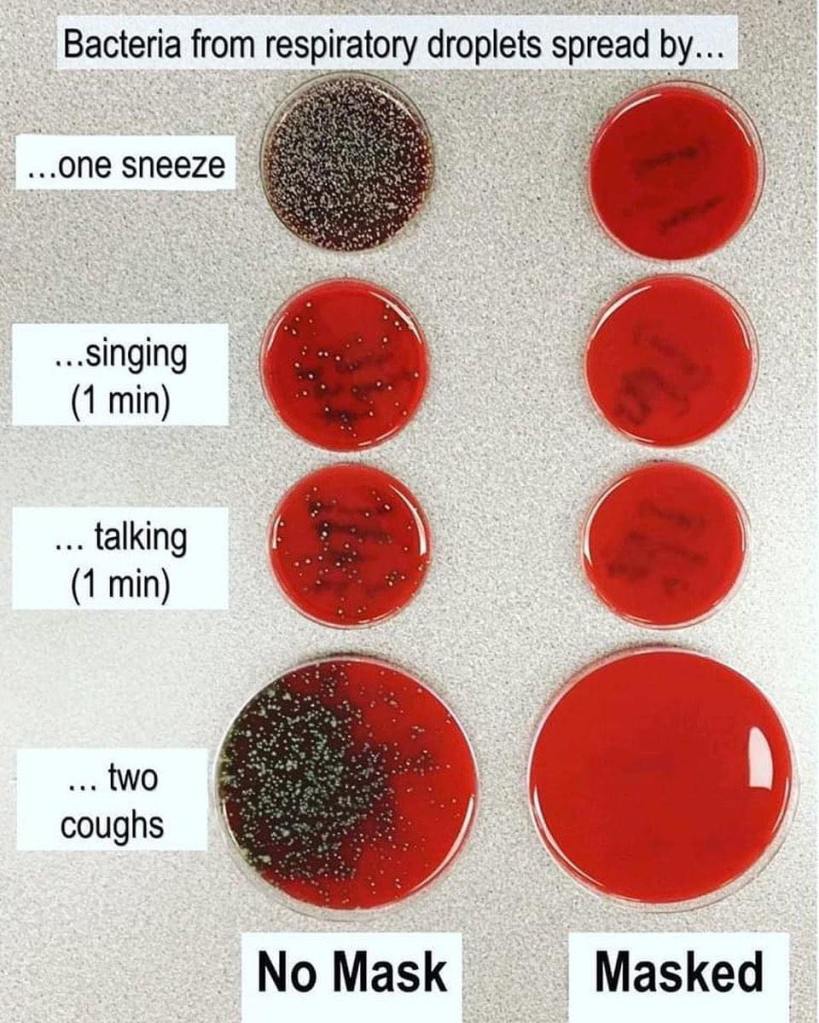

Sosyal medya “arkadaşlarımın” çoğu tatil yörelerinden güzel fotoğraflar paylaşıyorlar. Yazlıklarda kalabalık kahvaltı sofralarında demli çay bardaklarıyla ve gölgelerin uzadığı kerahat vakitlerinde tokuşturulan rakı kadehleri eşliğinde kameraya bakılıyor ve “musmutlu” gülen yüzler fotoğraf karesine düşüyor. Sonra uçuşan “like”lar ve “çok güzelsin canım” yorumlarına “o senin güzelliğin” cevapları geliyor.

Şimdiki cep telefonları bir harika, kameraları profesyonel makinalarla yarışıyor. Az önce sosyal medya arkadaşlarımdan birinin Facebook’da paylaştığı fotoğrafa takıldı gözüm. Geniş açıyla çekilmiş ve ayrıntılar çok net… Fotoğraf tatil yörelerimizden birinde denize yakın büyük bir kafeyi kaydetmiş. Fotoğraftaki gölgelerin şekline bakınca vaktin öğle veya öğleden hemen sonra olduğu anlaşılıyor. Kafenin işletmecisi oturma alanının üstünü tamamen kapatmış. Haddizatında, üstü açık olsa o sıcakta ve güneşte 10 dakika oturulmaz, bilemedin 15. Kafede oturacak masa kalmamış, “boşalacak yer olur mu” umuduyla bekleyen bir çift ayakta bakınıyor. Dedim ya, fotoğrafın çözünürlüğü çok iyi; arkası dönük olanlar ve diğerlerinin arkasında kalanlar dışında kimin kim olduğu net olarak belli oluyor. Saymasaydım olmazdı, tek tek maske takanları saydım.
Fotoğrafta yüzü görünenlerin toplam sayısı 22 kişiydi ve içlerinde 7, sadece yedi kişide maske vardı. Fotoğrafı büyüterek bakınca o yedi kişiden dördünün maskelerinin burnu açık veya maske çeneye indirilmiş durumdaydı. Nizami olarak maske takan 3 kişiden ikisi ise servis elemanı çalışanlardı. Oturanlar arasında tek başına oturan ve kitap okuyan maskeli bir kadın dışında kendini risk altında gören veya başkalarını riske atacağını düşünen tek kişi yoktu.

“Hava çok sıcak, virüsler bu sıcağa dayanamaz” veya “e ama orası açık havadaymış” gibi itirazlarınız varsa kendinize saklayın. O kafede oturan tek bir taşıyıcı 10-20 kişiye, belki daha fazlasına virüsü bulaştırabilir[i]. Açıkça yazacağım, bu şekilde o-tu-ra-maz-sı-nız!
18 Temmuz 2020 günü yeni bir rekor kırıldı. COVID-19 pandemisinin başlangıcından bu yana bütün dünyada bir günde en yüksek doğrulanmış olgu sayısının (259.848) ve yüksek ölüm sayılarından birinin (7360) kayıtlara geçtiği gün oldu[ii].

Aşağıdaki tabloda da 25 Temmuz itibarıyla dünyadaki vaka ve ölüm sayılarını görebilirsiniz. Lafı uzatmaya gerek yok, pek çok ülkenin vaka ve ölüm sayılarını doğru bildirmemesine rağmen net olarak görüyoruz: Pandemi bütün hızıyla sürüyor ve öldürüyor!

Dünyadaki pek çok ülke yönetimi artan vaka ve ölüm sayılarının sebebini halkın maske takma uyarılarına ve sosyal mesafeye uymaması olarak açıklıyor. Siyasi liderler pandemiyi yönetmekteki yetersizliklerini gizlemek için faturayı halka çıkardılar.

Siyasi ve ekonomik gücü elinde tutanlar artık şunu çok iyi biliyorlar: Pandemi en çok her gün işe gitmek zorunda olan, toplu ulaşım aracı kullanan ve dip dibe çalışan yoksulları, pek çok ülke yönetiminin yük olarak gördüğü yaşlıları ve huzurevlerinde yaşayanları, cezaevlerindeki mahkumları, göçmenleri, mültecileri öldürüyor. Dünyanın dört bir yanından gelen istatistik verilere bakın; ölenlerin çok büyük bir kesimi artık sömürülecek yanı kalmamış olanlardan oluşuyor. Ortaya çıkan tablonun faturasını uyarıları dikkate almayan halka kesen çıkar ve erk sahipleri durumdan memnunlar. Dünyayı yönetenler tüm ideolojik aygıtları kullanarak halkın ölümleri kanıksamasını, normalleşmekten başka çare kalmadığına inanmalarını, bütün bu olup bitenlerin çok büyük güçlerin projesi olduğuna ve değişmesinin olanaklı olmadığı fikrine saplanmalarını istedi! Tatil yörelerinden gelen fotoğrafları gördüğümde “evet başardılar” diyorum kendime. Çünkü bu fotoğrafları paylaşanlar güruh halinde Ayasofya açılışına tekbirlerle yürüyen, inançları akıllarından büyük “dini bütünler” değil; orta veya yüksek eğitime sahip, kendilerini sosyal demokrat, Atatürkçü, ulusalcı, solcu, devrimci, sosyalist, liberal olarak tanımlayanlardan oluşuyor.

Hani “açık havada oturuyoruz, ne olabilir ki” diyerek arkadaşları ile kafelerden selfi paylaşanlarınız var ya; dünyayı yöneten güçlerin elinde oyuncak olduklarını bile anlamaktan acizler [ıv). Gevrek ve sevimli gülücükleri, kollarına taktıkları maskeleriyle sosyal medyada “like” bekleyen arkadaşlarınıza iletin lütfen: Yaptıkları itirazlar, söyledikleri “ama, fakat” sözleri antik Roma’da gladyatörlerin birbirlerinin boğazlarını kesmeden önce imparatora söylediklerine benziyor, hatırlayın!
Ave caesar, morituri te salutant. Türkçesi: “Selam Sezar, biraz sonra ölecek olanlar seni selamlıyor.”
DİPNOTLAR
[i] Çin’de COVID-19 hastası bir kadının bindiği asansöre daha sonra binen 71 kişiye virüs bulaştığı bildirildi.
[ii] Prof. Dr. Kayıhan Pala, Twitter. 19 Temmuz 2020.
[iii] Kaynak: https://www.worldometers.info/coronavirus/#countries
[iv Açık havada bile olsanız, aynı evde yaşamayan kişilerin aralarında iki metre mesafe yoksa maske takmaları zorunludur. Etkili bir koruma için aralarındaki mesafe 2 metrenin altında olan kişilerin tümü maskeli olmalıdır ve maskeler usulüne uygun takılmalıdır. Kapalı yerlerde ise mesafe kaydı olmaksızın herkesin maskesi takması zorunludur.
izafi.org sitesinden daha fazla şey keşfedin
Son gönderilerin e-postanıza gönderilmesi için abone olun.
Doğan beyciğim, ne yazıkki bilim hiç bir şey bilmiyor(!) Geçmişte olağan üstü yığılmalar yoğunluklar yaşandı. 2 hafta sonta bulaşma patlaması olacak diyen bilim adamları yanıldı. Sağlık bakanımız her gün düzenli düşen grafikler veriler açıkladı. Halk elbette tv de en çok konuşan bakana inanıyor. Bazıları hiç hastalık olmadığına inanıyor. Dediğiniz gibi ekmeğini kazanmak zorunda olan emekciler inanmak zorunda. Fakar kendini birşey sanan bilmişlere şaşmamak elde değil. Onlarda kumar macerasını veya rus ruletini seviyor demekki!
BeğenBeğen
Doğan beyciğim, ne yazıkki bilim hiç bir şey bilmiyor(!) Geçmişte olağan üstü yığılmalar yoğunluklar yaşandı. 2 hafta sonta bulaşma patlaması olacak diyen bilim adamları yanıldı. Sağlık bakanımız her gün düzenli düşen grafikler veriler açıkladı. Halk elbette tv de en çok konuşan bakana inanıyor. Bazıları hiç hastalık olmadığına inanıyor. Dediğiniz gibi ekmeğini kazanmak zorunda olan emekciler inanmak zorunda. Fakar kendini birşey sanan bilmişlere şaşmamak elde değil. Onlarda kumar macerasını veya rus ruletini seviyor demekki!
Von meinem iPad gesendet
BeğenBeğen
Mecburen hasta bakan bir dişhekimi olarak, aldığım önlemlerin hastalarım tarafından olağanüstü bulunmasına ve inceden alay konusu olmaya epey alıştım.
Sahili sabahın altısından itibaren işgal eden maskesiz koşucu ve bisikletçilerle karşılaşmamak için sabahın beşinde nefes almaya gitmek zorunda olmaya sanki alıştım.
Tüm açık-kapalı mekanlarda çene altında, kollarda duran bez parçalarını, bağıra çağıra tükrük saçarak yapılan sohbetleri, çocuklara maske takılmamasını, petlerin, eşyaların gelişigüzel evlere sokulmasını, sigaraların binbir yere dokunmuş ellerle içilmesini görmeye de alıştım sayılır.
Ama şu yerlere atılmış kullanılmış eldiven ve maskelere dayanamıyorum. Anında tansiyonum çıkıyor. Dr. Bana bir çare?
BeğenLiked by 1 kişi
Muhteşem.
BeğenLiked by 1 kişi
Başıma kocaman bir taş düştü. Bizimki sürü psikolojisi. Etrafımdakiler takmayınca bende takmadım. Dersimi aldım. Maskesiz çıkmak yok.
BeğenLiked by 1 kişi
Çok sade ve net bir anlatım. Durum bu. Teşekkür ediyorum.
BeğenLiked by 1 kişi
Dehşetle okudum. Biz uyuyormuşuz haberimiz yok. Etrafımdaki herkesin kafasına vura vura okutacağım.
BeğenLiked by 1 kişi
Son günlerde giderek artan vakalar yazınızı doğruluyor. Çok anlaşılır ve net yazıyorsunuz. Tebrik ediyorum.
BeğenLiked by 1 kişi
Her yazınızı okuyorum. Bu çok iyi olmuş. Teşekkür ediyoru.
BeğenLiked by 1 kişi
Bu yazıyı Okuyanlar bilinçli, Okumayanlar ise maske takmaz. Dünyanın sonu geldi.
BeğenBeğen
Doğan hocam harikasınız. Hayranım size.
BeğenLiked by 1 kişi
Biz kendimizi korumak için kendimizi dünyadan izole ettik ama bu sorumsuzlar yüzünden bizler de tehlike altındayız. Lanet olsun bu insanlara.
BeğenBeğen
Doğan hocam yakında okullar açılacak. Bu şartlarda çocuklar ve biz risk altında mıyız. Bu konuda yazarmısınız. En çok size güveniyorum.
BeğenLiked by 1 kişi
Kötümser olmak istemem ama insanlığın sonu geldi sanıyorum.
BeğenBeğen
Bu yazıyı 1 yıl önce yazmışsınız, şimdi okudum. 1 yılda değişen yok. Aynı tas aynı hamam.
BeğenLiked by 1 kişi